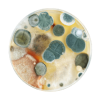

Дренажные системы для частного дома и дачи в Москве и МО с 2015 года
• сейчас работаем
Дренажные системы для частного дома и дачи в Москве и МО с 2015 года
• сейчас работаем
• сейчас работаем
В МОСКВЕ И МОСКОВСКОЙ ОБЛАСТИ
Собственные монтажные бригады
От 1 200 ₽ за метр с монтажом
Расширенная гарантия 5 лет по договору
Узнайте стоимость дренажа «под ключ» прямо сейчас и закрепите за собой скидку 25%!
Всем знакомая ситуация после начала активного таяния снега или после дождя во дворе образуется огромные лужи. Нередко такие наводнения приводят к серьезным последствиям:

Штукатурка начинает трескаться — это приводит к быстрому износу здания и сокращению эксплуатации в два раза

Вода просочиться в цокольный этаж и подвал, вследствие образуется сырость и плесень в помещении. Запасы продуктов, вещи и техника в таких условиях быстро испортятся

Далее плесень поднимается выше на жилые этажи поражая стены, обои, мебель. Что приводит к очень плохим последствиям и может подорвать ваше здоровье и близких

Стоячая вода отличная среда для москитов и мошек. При постоянном полчище кровососов о комфортной жизни говорить не приходится...

Во время ливней или таяния снега вода не уходит, и образуются лужи. В итоге приходится ходить в резиновой обуви постоянно

Из-за влажности и постоянных луж на участке земля не высыхает и ваш газон и посевы будут плохо приживаться и расти

Штукатурка начинает трескаться — это приводит к быстрому износу здания и сокращению эксплуатации в два раза
Вода просочиться в цокольный этаж и подвал, вследствие образуется сырость и плесень в помещении. Запасы продуктов, вещи и техника в таких условиях быстро испортятся

Далее плесень поднимается выше на жилые этажи поражая стены, обои, мебель. Что приводит к очень плохим последствиям и может подорвать ваше здоровье и близких

Стоячая вода отличная среда для москитов и мошек. При постоянном полчище кровососов о комфортной жизни говорить не приходится...

Во время ливней или таяния снега вода не уходит, и образуются лужи. В итоге приходится ходить в резиновой обуви постоянно

Из-за влажности и постоянных луж на участке земля не высыхает и ваш газон и посевы будут плохо приживаться и расти
Эти проблемы могут быть связаны с отсутствием или неправильно спроектированной и смонтированной дренажной системой на участке. Также с особенностью грунта и расположения участка и дома. Постоянные застои воды приводят к промерзанию грунта зимой, а фундамент при контакте с водой постепенно разрушается.

Подготовительный этап, на котором обследуют участок и выполняют проектирование для определения требования и характеристик дренажа

Укладывать трубы внутри дрены нужно с небольшим уклоном. Уклон должен быть равномерным по всей длине дрен. При нарушении уклона дренаж не будет работать правильно

Чтобы сэкономить на инженерной подготовке участка, дрены прокладывают на небольшой глубине. Они оказываются в зоне промерзания грунта и не обеспечивают отвод стоков от фундамента

Если не отсыпать траншеи песком, стоки будут плохо фильтроваться, что ускорит заиливание системы. Нельзя смешивать песок с существующим грунтом — это ухудшит проницаемость отсыпки

Их нельзя объединять, нагрузка на систему окажется слишком большой и ни одна из них не будет работать эффективно

Для разного вида грунта нужно подбирать разные решения (дренажные системы и геотекстиль). Иначе они быстро перестанут эффективно работать

Подготовительный этап, на котором обследуют участок и выполняют проектирование для определения требования и характеристик дренажа

Укладывать трубы внутри дрены нужно с небольшим уклоном. Уклон должен быть равномерным по всей длине дрен. При нарушении уклона дренаж не будет работать правильно

Чтобы сэкономить на инженерной подготовке участка, дрены прокладывают на небольшой глубине. Они оказываются в зоне промерзания грунта и не обеспечивают отвод стоков от фундамента

Если не отсыпать траншеи песком, стоки будут плохо фильтроваться, что ускорит заиливание системы. Нельзя смешивать песок с существующим грунтом — это ухудшит проницаемость отсыпки

Их нельзя объединять, нагрузка на систему окажется слишком большой и ни одна из них не будет работать эффективно

Для разного вида грунта нужно подбирать разные решения (дренажные системы и геотекстиль). Иначе они быстро перестанут эффективно работать
ДЕШЕВЫЙ
СРЕДНИЙ
ДОРОГОЙ
Онлайн
Старший менеджер по работе с клиентами
Пройдите этот тест, и я лично для Вас рассчитаю стоимость дренажа
ВЫ ПОЛУЧИТЕ ТОЧНЫЙ РАСЧЕТ СТОИМОСТИ ПОГРЕБА:
Расчет в 3-х вариантах цены
Скидка 25%
Вопрос 1
Вопрос 2
Вопрос 3
Вопрос 4

Вопрос 5
Тест пройден
Где Вам удобнее его получить?
СЕЙЧАС ВЫ ПОЛУЧИТЕ:
Расчет в 3-х вариантах цены
Скидку 25%
Вопрос 1
Вопрос 2
Вопрос 3
Вопрос 4

Вопрос 5
Тест пройден
Где Вам удобнее его получить?
СЕЙЧАС ВЫ ПОЛУЧИТЕ:
Расчет в 3-х вариантах цены
Скидку 25%
Мы осуществляем любые дренажные работы земельных участков, фундамента и дорожного полотна.

Поверхностный дренаж на глинистых почвах
Трубы залегают неглубоко и собирают только верховодку

Ливневая дождевая канализация
Система включает в себя дождеприемники, желоба с решетками и пескоуловители, соединенные трубами. Не стоит путать ливневку с дренажом

Пристенный дренаж цокольного этажа (подвала)
Выполняется так же, как дренаж фундамента, с тем отличием, что трубы прокладывают возле стен дома

Дренаж грунтовых вод
Трубы прокладывают по периметру участка. Важно правильно рассчитать систему, чтобы осушение было равномерным

Дренаж вокруг дома для отвода воды от фундамента
Трубы прокладывают по периметру дома, на расстоянии до 3 м. Трубы укладывают в слое щебня и оборачивают геотекстилем. Сверху делают обсыпку песком
990₽
890₽
990₽
Он замеряет уровень грунтовых вод, рассчитывается уклон и делает разметку будущей прокладки
Проводятся земляные работы — выкапываются траншеи соответственно выбранному виду дренажа.
Дно траншеи засыпается песком (отсыпная подушка около 10 см) или же щебнем и плотно утрамбовываются.
Прокладываются дрены и устанавливаются дренажные смотровые колодцы
Щебнем или гравием (не менее 20 см толщиной) и внахлест заворачивается геотекстиль
Снова делается песчаная подушка 10 сантиметрового слоя и утрамбовывается
В конце дренажной сети обустраивается точка сброса воды (коллекторный колодец)
Выравнивается поверхность участка с помощью выкопанной при рытье траншей земли
Он замеряет уровень грунтовых вод, рассчитывается уклон и делает разметку будущей прокладки
Проводятся земляные работы — выкапываются траншеи соответственно выбранному виду дренажа.
Дно траншеи засыпается песком (отсыпная подушка около 10 см) или же щебнем и плотно утрамбовываются.
Прокладываются дрены и устанавливаются дренажные смотровые колодцы
Щебнем или гравием (не менее 20 см толщиной) и внахлест заворачивается геотекстиль
Снова делается песчаная подушка 10 сантиметрового слоя и утрамбовывается
В конце дренажной сети обустраивается точка сброса воды (коллекторный колодец)
Выравнивается поверхность участка с помощью выкопанной при рытье траншей земли
Для физических лиц:
Оплата картой через терминал
Переводом на карту СберБанка
Оплата наличными деньгами
Для юридических лиц:
По реквизитам на расчётный счёт
Возможна оплата с НДС, и без НДС
Посмотрите, возможно, на Ваш вопрос уже есть ответ:
Какие типы дренажа есть?
Дренажные системы бывают закрытого и открытого типа. При открытом дренаже Вам понадобятся водоотводные лотки, решетки, дождеприемники, чтобы все это прикрыть. Что касается закрытого дренажа, то есть того, который находится под слоем земли, то понадобится больше материалов, труда и времени, но он и качество гарантирует более высокое качество.
Когда лучше установить дренажную систему?
Для предотвращения неприятностей дренажные системы лучше устанавливать до строительства дома, хотя если Вы уже построили фундамент и даже гидроизоляция подвала сделана, можете приступить к конструкции дренажа и на текущем этапе. Но при этом засыпка фундамента обязательно должна быть только после обустройства дренажа.
Зачем мне нужен выезд вашего специалиста на мой объект?
К Вам на объект выезжает не просто замерщик, а именно, инженер проектировщик, задача которого в первую очередь, определить Вашу проблему и предложить тот вид работ и метод гидроизоляции, при выполнении которых Вы решите Вашу проблему с водой раз и навсегда. Помимо определения такого решения, наш выездной инженер, произведет все нужные замеры и подробно проконсультирует Вас по вопросу предложенного им технологического решения.
Может ли поменяться стоимость в процессе/после завершения работ?
На зафиксированный в договоре объем работ стоимость измениться не может. Если при оказании услуг возникают дополнительные работы, которые не указаны в договоре, на них составляется дополнительная смета и согласовывается с Заказчиком до выполнения этих работ. Таким образом, вы всегда контролируете свой бюджет и избегаете лишних трат.
Нужно ли использовать смотровые колодцы?
Смотровые колодцы нужны обязательно. В местах резких поворотов создаются условия для заиливания и замусоривания со временем дренажа. Поэтому для дренажей дома, там где есть повороты на 90 градусов, мы всегда применяем смотровые колодцы. Если дом имеет правильную форму, то лучше ставить колодцы на всех углах. Если же форма дома более сложная и количество колодцев велико, то можно ставить смотровые колодцы через поворот.
Куда девается вода от дренажа?
Отвод воды является ключевым вопросом для дренажной системы. Можно сказать, что без возможности отвода воды функционирование дренажа невозможно и делать его нет смысла. Как правило вода собирается сборным колодец, который откачивает её за пределы участка - во внешнюю ливнёвку, в лоток, в кювет, в канаву, а иногда, просто на рельеф. Если рельеф позволяет то можно делать отвод дренажа за пределы участка без колодца. Если по геологии участка есть возможность сбросить воду в более глубокие слои, то делается более глубокий колодец и вода уходи, например, в песок, который присутствует на этой глубине.
Сколько ревизионных колодцев нужно ставить вокруг дома в системе дренажа?
Предпочтительно ставить колодцы на всех основных углах дома, так чтобы доступ для прочистки дренажной системы был со всех сторон дома!
и наш специалист перезвонит Вам, чтобы ответить на все интересующие вопросы
Адрес:
Москва, ул. Электродная, д. 11
Режим работы:
Пн-пт 9-18:00 сб-вс 10-19:00
Телефон:
Почта:

Проектируем и устанавливаем инженерные системы с 2019 года в Москве и Московской области